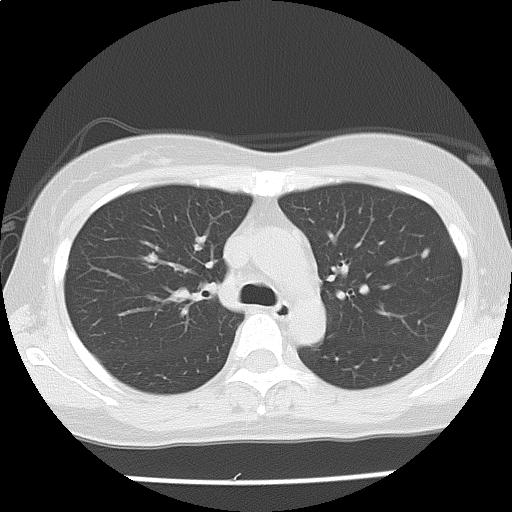
CT画像60

【画像診断検査結果】
(Findings)
両肺に径数 mm~約9 mm の結節が多発しており(添付画像以外にも認める)、辺縁不整を認める。
多発肺転移の可能性をまず除外する必要があり、原発としては乳癌、膵癌などと考える。
悪性が否定的な場合には、感染症、血管炎、サルコイドーシスなども鑑別に挙げられる。
縦隔リンパ節を散見する。胸水は認めない。
肝嚢胞を認める。
胆道系、膵、腎、副腎、脾に単純CTで指摘可能な明らかな病変を認めない。
子宮腫大を認め、筋腫が疑われるが、臨床経過との対比が望まれる
腹部に有意なリンパ節腫大は認めない。少量の腹水を認める。
(Impression)
多発肺結節・縦隔リンパ節腫大:r/o 多発肺転移
子宮腫大